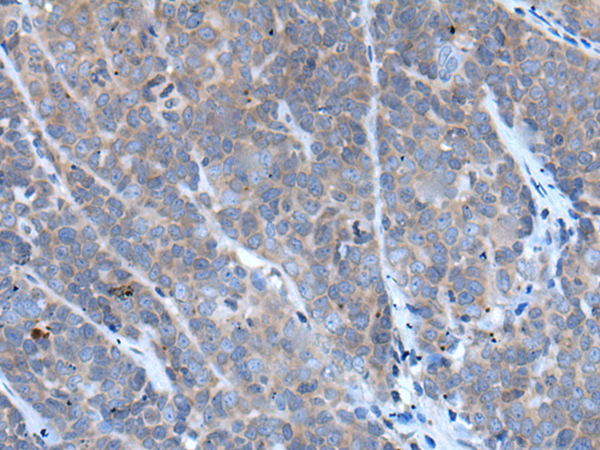

|
Background: |
The protein encoded by this gene is a member of the TNF-receptor superfamily. This receptor contains an extracellular TRAIL-binding domain and a transmembrane domain, but no cytoplasmic death domain. This receptor is not capable of inducing apoptosis, and is thought to function as an antagonistic receptor that protects cells from TRAIL-induced apoptosis. This gene was found to be a p53-regulated DNA damage-inducible gene. The expression of this gene was detected in many normal tissues but not in most cancer cell lines, which may explain the specific sensitivity of cancer cells to the apoptosis-inducing activity of TRAIL. |
|
Applications: |
ELISA, IHC |
|
Name of antibody: |
TNFRSF10C |
|
Immunogen: |
Fusion protein of human TNFRSF10C |
|
Full name: |
tumor necrosis factor receptor superfamily member 10c |
|
Synonyms: |
LIT; DCR1; TRID; CD263; TRAILR3; TRAIL-R3; DCR1-TNFR |
|
SwissProt: |
O14798 |
|
ELISA Recommended dilution: |
2000-5000 |
|
IHC positive control: |
Human liver cancer and human lung cancer |
|
IHC Recommend dilution: |
25-100 |
購物車
購物車 幫助
幫助
 021-54845833/15800441009
021-54845833/15800441009
